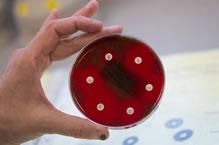

Severn Pathology

Pathology Services lie at the heart of patient care. Severn Pathology's mission is to provide a best in class, high quality, innovative, value for money pathology service that serves the needs of the healthcare market in the South West region and beyond. In doing so, we will strive to put pathology at the heart of a modern patient pathway, serving an increasingly diverse market.
Severn Pathology is located at Southmead Hospital Bristol. The hospital is approx. 4 miles from the main M4/M5 interchange with easy access to the main arterial road network, rail infrastructure, airports and ports.
Test Information

Includes details of sample types, volumes, special precautions, turnaround times & reference ranges.
Transport
Within North Bristol NHS Trust & for Primary Care locations where Pathology Services are provided by us.
Phlebotomy

The Pathology Phlebotomy Team based in the Brunel building at Southmead Hospital Bristol.